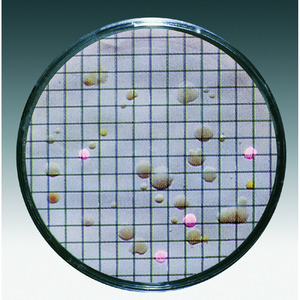

Atributos del producto
Seleccione qué atributos adicionales desea mostrar en la tabla a continuaciónProducto | Descripción | Packaging | Cant. | Precio € | Disponibilidad | Añadir al carrito | ||
---|---|---|---|---|---|---|---|---|
LLG09055015 | "Nutrient pads ""Lysin""pack of 100/100" | 100 pz. |
El producto LLG09055015 ya no está en producción
|
|||||
LLG09055019 | "Nutrient pads ""weman""pack of 100/100" | 100 pz. |
El producto LLG09055019 ya no está en producción
|
|||||
LLG09055025 | Nutrient pads glucose-tryptonpack o/100 | 100 pz. |
El producto LLG09055025 ya no está en producción
|
|||||
LLG09055028 | Nutient pads Schaufus-Pottinger | 100 pz. |
El producto LLG09055028 ya no está en producción
|
|||||
Leyenda
Disponible
Disponible en 15 dÍas
Disponible en 30 dÍas
Disponible en mÁs de 30 días
Agregado a su carrito de compras
Discos para cultivo
Discos para cultivo estériles y deshidratados en placas de Petri. Una vez que se humedecen con 3,0 ml a 3,5 ml de agua estéril y desmineralizada (o destilada), están listos para usar inmediatamente.Todos los medios de cultivo se suministran con filtros de membrana adecuados, envasados individualmente y estériles. Vida útil de entre 18 y 24 meses a temperatura ambiente.